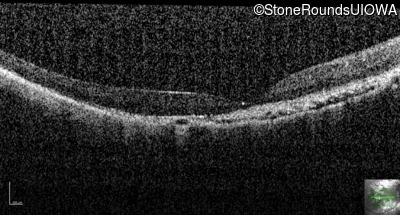
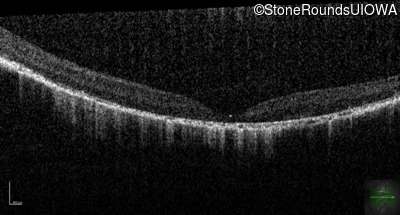
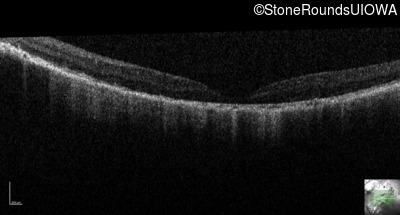
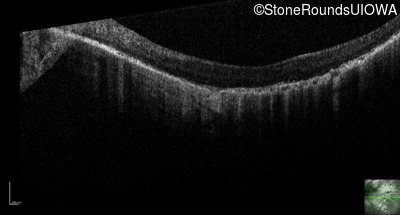

Case
SR161
Student Mode
Boucher-Neuhauser Syndrome (IIIA5i)
Female
Female
Hidden
SR161
Student Mode
Boucher-Neuhauser Syndrome (IIIA5i)
Female
Female
History
This 12 year old girl has had poor night vision and subnormal acuity since she was about 3 years old.
| Age at visit: 9 years |
| OD | |||
|---|---|---|---|
| Age at visit: 12 years (Visit 2) |
| Age at visit: 14 years |
| Age at visit: 16 years |
Diagnosis & molecular findings
| Disease | Gene | Allele 1 variant(s) | Allele 2 variant(s) | Inheritance mode |
|---|---|---|---|---|
| Boucher-Neuhauser Syndrome | PNPLA6 | Ala1064Thr GCC>ACC | Arg1135Trp CGG>TGG | AR |
Disease:
Gene:
Allele 1:
Ala1064Thr GCC>ACC
Allele 2:
Arg1135Trp CGG>TGG
Inheritance:
AR